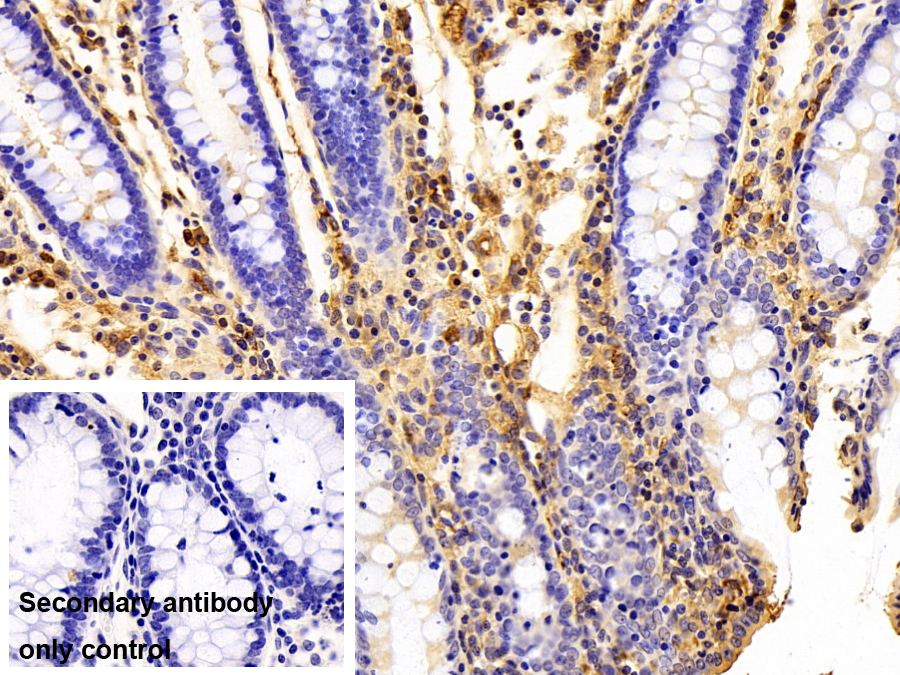

Polyclonal Antibody to Immunoglobulin M (IgM)
IGHM; Immunoglobulin Heavy Constant Mu; Ig mu chain C region
- Product No.PAA543Po01
- Organism SpeciesSus scrofa; Porcine (Pig) Same name, Different species.
- SourcePolyclonal antibody preparation
- HostRabbit
- Potencyn/a
- Ig Type IgG
- PurificationAntigen-specific affinity chromatography followed by Protein A affinity chromatography
- LabelNone
- Immunogen NPA543Po01-Native Immunoglobulin M (IgM)
- Buffer FormulationPBS, pH7.4, containing 0.02% NaN3, 50% glycerol.
- TraitsLiquid
- Concentration0.5mg/mL
- Organism Species Moren/a
- ApplicationsWB,IHC
If the antibody is used in flow cytometry, please check FCM antibodies. - Downloadn/a
- UOM 20µl100µl 200µl 1ml 10ml
- FOB
US$ 96
US$ 224
US$ 320
US$ 800
US$ 3200
For more details, please contact local distributors!
SPECIFITY
The antibody is a rabbit polyclonal antibody raised against IgM. It has been selected for its ability to recognize IgM in immunohistochemical staining and western blotting.
USAGE
Western blotting: 0.01-2µg/mL;
Immunohistochemistry: 5-20µg/mL;
Optimal working dilutions must be determined by end user.
STORAGE
Store at 4°C for frequent use. Stored at -20°C in a manual defrost freezer for two year without detectable loss of activity. Avoid repeated freeze-thaw cycles.
STABILITY
The thermal stability is described by the loss rate. The loss rate was determined by accelerated thermal degradation test, that is, incubate the protein at 37°C for 48h, and no obvious degradation and precipitation were observed. The loss rate is less than 5% within the expiration date under appropriate storage condition.
GIVEAWAYS
INCREMENT SERVICES
-
 Antibody Labeling Customized Service
Antibody Labeling Customized Service
-
 Protein A/G Purification Column
Protein A/G Purification Column
-
 Staining Solution for Cells and Tissue
Staining Solution for Cells and Tissue
-
 Positive Control for Antibody
Positive Control for Antibody
-
 Tissue/Sections Customized Service
Tissue/Sections Customized Service
-
 Phosphorylated Antibody Customized Service
Phosphorylated Antibody Customized Service
-
 Western Blot (WB) Experiment Service
Western Blot (WB) Experiment Service
-
 Immunohistochemistry (IHC) Experiment Service
Immunohistochemistry (IHC) Experiment Service
-
 Immunocytochemistry (ICC) Experiment Service
Immunocytochemistry (ICC) Experiment Service
-
 Flow Cytometry (FCM) Experiment Service
Flow Cytometry (FCM) Experiment Service
-
 Immunoprecipitation (IP) Experiment Service
Immunoprecipitation (IP) Experiment Service
-
 Immunofluorescence (IF) Experiment Service
Immunofluorescence (IF) Experiment Service
-
 Buffer
Buffer
-
 DAB Chromogen Kit
DAB Chromogen Kit
-
 SABC Kit
SABC Kit
-
 Long-arm Biotin Labeling Kit
Long-arm Biotin Labeling Kit
-
 Real Time PCR Experimental Service
Real Time PCR Experimental Service
| Magazine | Citations |
| Poultry Science | Effects of Clostridium butyricum on growth performance, immune function, and cecal microflora in broiler chickens challenged with Escherichia coli K88 Pubmed: 24570422 |
| Clin Vaccine Immunol. | Speci?c Humoral Immune Response Induced by Propionibacterium acnes Can Prevent Actinobacillus pleuropneumoniae Infection in Mice Pubmed:24429068 |
| Asian J Pharm Clin Res | INFLUENCE OF ZINCOVIT DROP (NUTRITIONAL FOOD SUPPLEMENT) ON IMMUNE SYSTEM IN NORMAL AND CYCLOPHOSPHAMIDE INTOXICATED WISTAR RATS journals:3790 |
| Food and Agricultural Immunology | Effects of fermented cottonseed meal on growth performance, serum biochemical parameters, immune functions, antioxidative abilities, and cecal microflora in broilers 10.108:09540105.2017.1311308 |
| International Journal of Clinical and Experimental Medicine | Detection of streptococcus pyogenes antibodies in acute idiopathic urticaria ISSN:1940-5901/IJCEM0053690 |
| Food and Agricultural Immunology | Effects of and on growth performance, immune function and volatile fatty acid level of caecal digesta in broilers 10.1080:09540105.2018.1457013 |
| SAGE Open Medicine | Altered immunoglobulins (A and G) in Ghanaian patients with type 2 diabetes Pubmed:29623201 |
| International Journal of Biological Macromolecules | Effects of polysaccharides from Yingshan Yunwu tea on meat quality, immune status and intestinal microflora in chickens Pubmed: 32224178 |
| INTERNATIONAL JOURNAL OF BIOLOGICAL MACROMOLECULES | Physicochemical characterization and immunomodulatory activity of sulfated Chinese yam polysaccharide Pubmed: 33010421 |
| BIOLOGICAL TRACE ELEMENT RESEARCH | Association Between Serum Selenium Level and Subclinical Mastitis in Dairy Cattle Pubmed: 32583225 |
| IMMUNOSTIMULATORY EFFECT OF MORINGA OLEIFERA LEAVES EXTRACT ON CYCLOPHOSPHAMIDE-INDUCED IMMUNOSUPPRESSION IN MICE | |
| Journal of Functional Foods | Comparison of immunomodulatory effects of three polysaccharide fractions from Lentinula edodes water extracts |
| Italian Journal of Animal Science | Effects of chitooligosaccharide supplementation on laying performance, egg quality, blood biochemistry, antioxidant capacity and immunity of laying hens during the … |
| Regenerative Biomaterials | A comparative study of autogenous, allograft and artificial bone substitutes on bone regeneration and immunotoxicity in rat femur defect model |
| 博士论文 | Women Scientist Scientist Mentor |
| Life Sci | Celecoxib ameliorates liver cirrhosis via reducing inflammation and oxidative stress along spleen-liver axis in rats 33577848 |
| Mol Med Rep | Baicalin relieves Mycoplasma pneumoniae infection?induced lung injury through regulating microRNA?221 to inhibit the TLR4/NF?¦ÊB signaling pathway 34109422 |
| Environ Pollut | Trace endotoxin in reclaimed water is only one of the risk sources in subchronic inhalation exposure 34090073 |
| British Journal of Pharmacology | The suppression of Brd4 inhibits peripheral plasma cell differentiation and exhibits therapeutic potential for systemic lupus erythematosus |
| Journal of Herbs, Spices & Medicinal Plants | Immunostimulatory Effect of Moringa oleifera Extracts on Cyclophosphamide-induced Immunosuppressed Mice |
| Microbiology Spectrum | Dietary Supplementation of Inulin Ameliorates Subclinical Mastitis via Regulation of Rumen Microbial Community and Metabolites in Dairy Cows 34494854 |
| Food Research International | Sulfated modification enhances the immunomodulatory effect of Cyclocarya paliurus polysaccharide on cyclophosphamide-induced immunosuppressed mice through … 34865774 |
| Food Funct | Three Urban of China: A Cohort Study of Maternal-Infant Factors and HM Protein Components Pubmed:35438093 |
| Catalog No. | Related products for research use of Sus scrofa; Porcine (Pig) Organism species | Applications (RESEARCH USE ONLY!) |
| NPA543Po01 | Native Immunoglobulin M (IgM) | Positive Control; Immunogen; SDS-PAGE; WB. |
| RPA543Po01 | Recombinant Immunoglobulin M (IgM) | Positive Control; Immunogen; SDS-PAGE; WB. |
| PAA543Po01 | Polyclonal Antibody to Immunoglobulin M (IgM) | WB,IHC |
| SEA543Po | ELISA Kit for Immunoglobulin M (IgM) | Enzyme-linked immunosorbent assay for Antigen Detection. |
| LMA543Po | Multiplex Assay Kit for Immunoglobulin M (IgM) ,etc. by FLIA (Flow Luminescence Immunoassay) | FLIA Kit for Antigen Detection. |